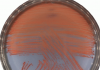

깊은 울림 전한 전남 시니어 합창단 경연대회 성료
25개 팀 1천여 명 참여…나주 은파합창단 최우수상
탁상훈 기자입력 : 2025. 10. 30(목) 17:13

전남도 시니어합창 경연대회 시상식
[한국뉴스저널]전남지역 어르신들이 깊이 있는 하모니를 선보인 제9회 전남도 시니어합창 경연대회에서 나주 은파합창단이 최우수상의 영예를 안았다.
전라남도는 30일 도청 김대중강당에서 시니어합창단 25개 팀 1천여 명이 참여한 시니어 합창 경연대회가깊은 울림 전한 전남 시니어 합창단 경연대회 성료, 추가 보도자료입니다. 성황리에 막을 내렸다고 밝혔다.
평균 연령 70세를 넘나드는 어르신들의 선보인 깊이 있는 하모니는 관객들로부터 뜨거운 박수갈채를 받았으며, 연륜에서 우러나는 감성적 표현력으로 무대를 가득 채웠다.
특히 지난해에 이어 올해도 온라인 생중계를 통해 가족과 지역민이 함께 감상할 기회를 제공해 큰 호응을 얻었다.
경연 결과 최우수상에 나주 은파합창단이, 우수상에 영광 산울림시니어합창단, 목포 풀잎합창단, 강진 6070합창단이 각각 수상 영예를 안았다.
정광선 전남도 보건복지국장 “그동안 어르신들께서 화합하고 성원해준 덕분에 최근 전남도가 대한민국 AI 수도로서 미래의 성장동력을 만들어 낼 엄청난 기회가 왔다”며 “어르신들께서 물려준 이 자랑스러운 전남을 후손들에게 더욱 찬란하게 물려주도록 최선을 다하겠다”고 말했다.
음악 활동은 어르신의 인지기능 향상과 우울감 해소, 사회적 유대감 증진에 도움을 주며, 건강한 노후를 위한 중요한 문화 활동으로 자리잡고 있다. 전남도는 어르신의 적극적인 사회참여와 삶의 활력 증진 도모를 위해 2015년부터 매년 전남도 시니어 합창 경연대회를 계속 개최하고 있다.
전라남도는 30일 도청 김대중강당에서 시니어합창단 25개 팀 1천여 명이 참여한 시니어 합창 경연대회가깊은 울림 전한 전남 시니어 합창단 경연대회 성료, 추가 보도자료입니다. 성황리에 막을 내렸다고 밝혔다.
평균 연령 70세를 넘나드는 어르신들의 선보인 깊이 있는 하모니는 관객들로부터 뜨거운 박수갈채를 받았으며, 연륜에서 우러나는 감성적 표현력으로 무대를 가득 채웠다.
특히 지난해에 이어 올해도 온라인 생중계를 통해 가족과 지역민이 함께 감상할 기회를 제공해 큰 호응을 얻었다.
경연 결과 최우수상에 나주 은파합창단이, 우수상에 영광 산울림시니어합창단, 목포 풀잎합창단, 강진 6070합창단이 각각 수상 영예를 안았다.
정광선 전남도 보건복지국장 “그동안 어르신들께서 화합하고 성원해준 덕분에 최근 전남도가 대한민국 AI 수도로서 미래의 성장동력을 만들어 낼 엄청난 기회가 왔다”며 “어르신들께서 물려준 이 자랑스러운 전남을 후손들에게 더욱 찬란하게 물려주도록 최선을 다하겠다”고 말했다.
음악 활동은 어르신의 인지기능 향상과 우울감 해소, 사회적 유대감 증진에 도움을 주며, 건강한 노후를 위한 중요한 문화 활동으로 자리잡고 있다. 전남도는 어르신의 적극적인 사회참여와 삶의 활력 증진 도모를 위해 2015년부터 매년 전남도 시니어 합창 경연대회를 계속 개최하고 있다.